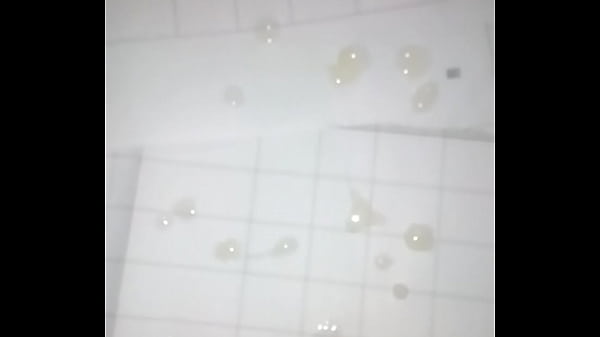
video

Sunny Leone Bisexual Sex Videos - Sunny Leone Bisexual
Sunny Leone Bisexual Porn Videos Download
Sunny Leone Bisexual - Porn Videos Sunny Leone Bisexual Sex Video
All results of porn videos for sunny leone bisexual, Watch and download huge collection of sunny leone bisexual sex video in simple and easy way, XXX HD fresh and full sunny leone bisexual porn videos available here free of cost.
HotXV is a simple and free platform of porn videos. Note: You must be 18 or older to access this adult website.